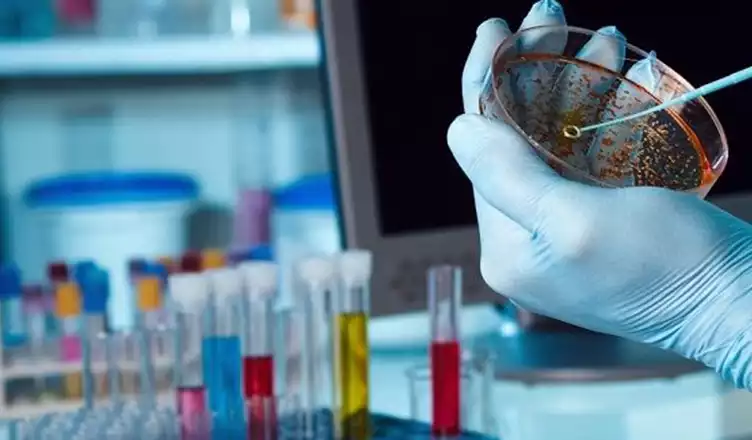

Özel Medlife Klinigi Bodrum SGK Anlaşmalı Medlife Bodrum, doğru tanı ve tedavi yöntemleriyle sağlık sektöründe öncü olmayı hedefleyen, hasta hak ve sorumluluklarını gözeten, yüksek standartlarda ve nitelikli tıbbi hizmet sunmayı amaçlayan bir sağlık kuruluşudur.
Bodrum Konacık Bitez Kavşağı bölgesinde hizmet vermektedir.

Özel Medlife Kliniği Bodrum
Medlife Tıp Merkez
Medlife Clinic Ambulance
Medlife Tıp Merkezi
📞 İletişim Bilgileri
☎ Telefon
0 252 363 77 76
0 252 363 00 79
0 543 627 74 01
✉ E-posta
info@medlifetipmerkezi.com
🌐 Web Sitesi
medlifetipmerkezi.com
📍 Adres
Konacık Mahallesi, Atatürk Bulvarı No:203/B Bodrum / Muğla – Bitez Kavşağı
Özel Medlife Klinigi Bodrum, doğru tanı ve tedavi yöntemleriyle sağlık sektöründe öncü olmayı hedefleyen; hasta hak ve sorumluluklarını gözeten, yüksek standartlarda ve nitelikli tıbbi hizmet sunmayı amaçlayan bir sağlık kuruluşudur.
Merkezimiz; Sosyal Güvenlik Kurumu (SSK, BAĞ-KUR, Emekli Sandığı), devlet memurları ve 18 yaş altı sosyal güvenlik kapsamında olmayan bireyler ile kurum anlaşmalarına sahiptir. MEDLIFE Tıp Merkezi, Bodrum Bitez Kavşağı’nda hizmet vermektedir.
Sağlıklı bir toplum anlayışıyla, hasta memnuniyeti odaklı ve tıbbi etik değerler çerçevesinde yüksek kalitede sağlık hizmeti sunmak temel ilkemizdir.
Çağdaş altyapısı, en son teknolojiyi kullanan deneyimli ekibi ve uluslararası sağlık standartlarını benimseyen yaklaşımıyla; tedavi edici uygulamaların yanı sıra koruyucu sağlık hizmetlerine de önem veren, bölgemizde ve Türkiye genelinde saygın ve referans bir sağlık kuruluşu olmayı hedeflemektedir.
Sağlığınız önceliğimizdir.
Özel Medlife Kliniği Bodrum, uzman doktorlarımız ve deneyimli kadromuz ile Bodrum, Konacık ve Bitez Kavşağı bölgesinde hizmet vermektedir.
Muayene – Teşhis – Tedavi
Doğru tedavi ancak doğru teşhisle mümkündür. Doğru tanı koymak ve en uygun tedaviyi uygulamak temel hedefimizdir.
Acil Servis ve İlk Müdahale
Acil Sağlık Hizmetleri Birimi’ne başvuran tüm hastalar, sağlık güvencesi ve ödeme durumu gözetilmeksizin kabul edilir.
Uzman Doktor Kadrosu
Akademik değerlere önem veren, alanında yetkin ve deneyimli tıbbi kadromuz ile hizmetinizdeyiz. Doktorlarımıza bölüm isimleri üzerinden ulaşabilirsiniz.
Poliklinikler ve Laboratuvar
Polikliniklerimiz, tıbbi teşhisin ayrılmaz bir parçası olan laboratuvar hizmetleriyle birlikte çalışmaktadır. Laboratuvar hizmetlerimiz SGK ile anlaşmalıdır.
Medikal Estetik Bölümünüz Var mı?
Evet. Bünyemizde Medikal Estetik Bölümü bulunmaktadır. Uzman kadromuzla hizmet vermekteyiz. Detaylı bilgi için Polikliniklerimiz sayfasını ziyaret edebilirsiniz.
Acil Servisiniz Var mı?
Evet. Ani gelişen veya katlanılmaz olarak değerlendirilen durumlarda acil servise başvurabilirsiniz. Nefes darlığı, göğüs ağrısı, bilinç değişikliği, ateş ve karın ağrısı gibi belirtiler yaşamı tehdit eden bir durumun habercisi olabilir. Özel Medlife Klinigi Bodrum
Kan Testi Yapıyor musunuz?
Evet. MEDLIFE Tıp Merkezi bünyesinde laboratuvar bulunmaktadır. Tüm kan testleri ve birçok tetkik yapılmakta olup, sonuçlar genellikle aynı gün çıkmaktadır.
Randevu Alabilir miyim?
Evet. Telefon numaralarımızdan bize ulaşarak veya merkezimize gelerek randevu alabilirsiniz.
Sağlık Raporu Veriyor musunuz?
Evet. Ehliyet, spor, iş, amatör denizcilik belgesi ve havuz için sağlık raporları verilmektedir.
SGK’lıyım, MEDLIFE’in SGK Anlaşması Var mı?
Evet. MEDLIFE Tıp Merkezi SGK ile anlaşmalıdır. Özel Medlife Klinigi Bodrum
Medlife Tıp Merkezi Bodrum Poliklinikler
Kardiyoloji
Kardiyoloji Bölümü; kalp ve dolaşım sistemi hastalıklarının tanı, tedavi ve takibini yapan tıbbi birimdir. Geçmişte İç Hastalıkları’nın bir alt dalı olarak değerlendirilen kardiyoloji, günümüzde bağımsız bir anabilim dalı olarak hizmet vermektedir.
Bölümümüzde; yüksek tansiyon (hipertansiyon), kalp ritim bozuklukları, koroner arter hastalıkları, kalp yetmezliği, kalp kapak hastalıkları ve dolaşım sistemi bozukluklarının tanı ve tedavisi yapılmaktadır. Özel Medlife Klinigi Bodrum
Hastalarımız; ayrıntılı klinik değerlendirme, gerekli tetkikler ve modern tanı yöntemleri eşliğinde ele alınmakta, hastalığın seyrine göre kişiye özel tedavi ve takip planları oluşturulmaktadır. Amaç; kalp sağlığının korunması, erken tanı ile olası risklerin önlenmesi ve yaşam kalitesinin artırılmasıdır.
Kardiyoloji Polikliniği, diğer branşlarla koordineli şekilde çalışarak multidisipliner yaklaşımı esas almaktadır.
Genel Cerrahi
Genel Cerrahi Bölümü; vücutta oluşan sistemik ve lokal hastalıkların cerrahi yöntemlerle tanı ve tedavisini kapsayan, tıbbın temel ve geniş kapsamlı branşlarından biridir. Birçok cerrahi ve temel tıp dalının gelişimine katkı sağlayan genel cerrahi, tanıdan tedaviye kadar geniş bir uygulama alanına sahiptir.
Bölümümüzde; karın içi organ hastalıkları, safra kesesi ve safra yolları hastalıkları, fıtıklar, yumuşak doku kitleleri, tiroid ve meme hastalıkları gibi birçok cerrahi rahatsızlığın değerlendirilmesi ve tedavisi yapılmaktadır.
Hastalarımız, ayrıntılı muayene ve gerekli tetkikler sonrasında uzman hekimler tarafından değerlendirilmekte; cerrahi gerektiren durumlarda en uygun ve güvenli tedavi yöntemi planlanmaktadır. Tedavi sürecinde hasta güvenliği, tıbbi etik ve modern cerrahi yaklaşımlar esas alınmaktadır.
Medikal Estetik
Medlife Tıp Merkezi’nde sunulan medikal estetik uygulamaları, cerrahi müdahaleye gerek kalmadan cildi yenilemeyi, yaşlanma belirtilerini azaltmayı ve doğal güzelliği ön plana çıkarmayı hedefler. Uzman hekimlerimiz tarafından güvenle gerçekleştirilen işlemler; kısa sürede etkili, doğal ve dengeli sonuçlar sunar.
Neden Medikal Estetik?
Medikal estetik yalnızca dış görünümü iyileştirmekle kalmaz; kişinin kendini daha özgüvenli ve iyi hissetmesine de katkı sağlar. Doğru yöntemlerle, cildin doğal yapısı korunur, yaşlanma süreci yavaşlatılır ve sağlıklı bir görünüm desteklenir. Özel Medlife Klinigi Bodrum
Uygulamalarımız
Medlife Tıp Merkezi’nde uygulanan başlıca medikal estetik yöntemleri şunlardır:
- Botoks Uygulamaları: Mimik kırışıklıklarını azaltarak daha pürüzsüz ve dinlenmiş bir görünüm kazandırır.
- Dolgu Uygulamaları: Yüzdeki hacim kayıplarını giderir; dudak, yanak ve yüz hatlarını daha belirgin hale getirir.
- Lazer Epilasyon: Ağrısız ve kalıcı çözümlerle istenmeyen tüylerden kurtulma imkânı sunar.
- Mezoterapi ve Gençlik Aşısı: Vitamin, mineral ve hyaluronik asit içerikleriyle cildin elastikiyetini ve parlaklığını artırır.
- Altın İğne ve Leke Tedavileri: Cilt yenilenmesini destekler, iz ve leke görünümünü azaltmaya yardımcı olur.
- Cilt Bakım Uygulamaları: Cildin ihtiyacına özel profesyonel bakım protokolleriyle canlı ve taze bir görünüm sağlar.
Güvenli, Konforlu ve Etkili
Tüm medikal estetik işlemleri, alanında uzman hekimler ve sağlık profesyonelleri tarafından, uluslararası güvenlik standartlarına uygun şekilde uygulanmaktadır. Kişiye özel planlanan tedaviler sayesinde abartıdan uzak, doğal ve dengeli sonuçlar elde edilir. Özel Medlife Klinigi Bodrum
✨ Medlife Estetik ile cildinizi yenileyin, güzelliğinizi güvenle keşfedin.
Göz Polikliniği
Göz Polikliniği, göz sağlığının korunması ve görme ile ilgili hastalıkların tanı, tedavi ve takibini yapan birimdir. Göz hastalıklarında erken tanı, görme kaybının önlenmesi açısından büyük önem taşımaktadır. Özel Medlife Klinigi Bodrum
Polikliniğimizde; görme bozuklukları, göz tansiyonu (glokom), katarakt, göz enfeksiyonları, alerjik göz hastalıkları, retina ve kornea ile ilgili rahatsızlıkların muayene ve takibi yapılmaktadır. Özel Medlife Klinigi Bodrum
Ayrıntılı göz muayenesi ve gerekli tetkikler ile hastalar değerlendirilmekte, hastalığın türüne ve seyrine göre uygun tedavi ve izlem planları oluşturulmaktadır. Amaç; sağlıklı görmenin korunması ve yaşam kalitesinin artırılmasıdır.
Diş Polikliniği
Diş Polikliniği, ağız ve diş sağlığının korunması, mevcut problemlerin erken tanı ile tedavi edilmesi ve düzenli kontrollerin sağlanması amacıyla hizmet vermektedir. Ağız ve diş sağlığı, genel sağlığın ayrılmaz bir parçasıdır.
Polikliniğimizde; diş muayenesi, diş taşı temizliği, dolgu uygulamaları, kanal tedavisi, diş çekimi ve ağız hijyenine yönelik koruyucu uygulamalar yapılmaktadır.
Hastalarımız, ayrıntılı ağız ve diş muayenesi sonrasında değerlendirilmekte; ihtiyaçlara göre kişiye özel tedavi planları oluşturulmaktadır. Tedavi sürecinde hijyen, hasta konforu ve modern diş hekimliği uygulamaları ön planda tutulmaktadır.
Fizik Tedavi ve Rehabilitasyon
Ortopedik Fizyoterapi
Bel fıtığı, bel ağrıları, boyun fıtığı, boyun ağrıları, boyun düzleşmesi, sinir sıkışmaları, fibromiyalji, omuz ağrıları, eklem kireçlenmesi (osteoartrit), diz kireçlenmesi, çapraz bağ yaralanmaları, tortikollis, menisküs yaralanmaları, skolyoz, topuk dikeni, bursit ve tendinit, bel kayması, ayak bileği burkulmaları, tetik nokta tedavileri, karpal tünel sendromu, donuk omuz sendromu, omuz sıkışma sendromu, omuz kas yırtıkları, kalça kireçlenmesi,Aşil tendiniti, halluks valgus, Baker kisti, parmak ucunda yürüme, çocuk diz ağrıları, düz taban, kırık rehabilitasyonu, tenisçi ve golfçü dirseği, kemik iliği ödemi, diz protezi rehabilitasyonu, kalça protezi rehabilitasyonu, spinal stenoz (kanal daralması). Özel Medlife Klinigi Bodrum
Nörolojik Fizyoterapi
İnme rehabilitasyonu, felç rehabilitasyonu, CP (Serebral Palsi) rehabilitasyonu, pediatrik rehabilitasyon, kas hastalıkları, Multipl Skleroz (MS), yüz felci rehabilitasyonu, omurilik yaralanmaları rehabilitasyonu, spina bifida rehabilitasyonu, brakiyal pleksus rehabilitasyonu, travmatik beyin hasarı rehabilitasyonu.
Dahiliye (İç Hastalıkları)
Dahiliye (İç Hastalıkları) Bölümü, yetişkin hastalarda iç organları ilgilendiren hastalıkların tanı, tedavi ve takibini yapan temel tıbbi branşlardan biridir. Hastayı bütüncül ve objektif şekilde değerlendirmek, bu bölümün temel yaklaşımıdır. Birçok sistemik hastalıkta ilk başvurulan birim olan Dahiliye, doğru tanıya ulaşmada ve tedavi sürecinin planlanmasında önemli rol oynar. Özel Medlife Klinigi Bodrum
Bölümümüzde; diyabet (şeker hastalığı), hipertansiyon (tansiyon), karaciğer hastalıkları, böbrek hastalıkları, kan hastalıkları, sindirim sistemi (mide ve bağırsak) hastalıkları, enfeksiyon hastalıkları, solunum sistemi rahatsızlıkları, hormon bozuklukları ve obezite gibi pek çok hastalığın tanı ve tedavisi yapılmaktadır.
Ayrıntılı hasta öyküsü ve fizik muayene sonrasında gerekli laboratuvar tetkikleri ve görüntüleme yöntemleri uygulanmakta, elde edilen bulgular doğrultusunda kişiye özel tedavi planı oluşturulmaktadır. Gerekli durumlarda diğer branşlarla iş birliği yapılarak multidisipliner bir yaklaşım benimsenmektedir.
Gebelikte Tiroid Bezi Kontrolü
Gebelik sürecinde tiroid hormon düzeylerinde değişiklikler görülebilir. Tiroid hastalıklarının belirtileri gebelikte sık rastlanan şikâyetlerle benzerlik gösterebildiğinden, tanı gecikebilir. Gebelikte gelişen tiroid hormon yetersizliği; anne ve bebeğin sağlığını olumsuz etkileyebilir, erken doğum ve düşük doğum ağırlığı gibi riskler oluşturabilir. Özel Medlife Klinigi Bodrum
Bu nedenle gebelik öncesinde ve gebeliğin özellikle ilk üç ayında tiroid hormon düzeylerinin kontrol edilmesi büyük önem taşır. Gerekli durumlarda erken dönemde tedavi planlanarak anne ve bebek sağlığı güvence altına alınır.
Dahiliye Polikliniği, doğru tanı, düzenli takip ve etkili tedavi yaklaşımıyla hastaların yaşam kalitesini artırmayı hedeflemektedir.
Kadın Hastalıkları-Doğum
Kadın Hastalıkları ve Doğum ile ilgili genel tanı ve tedavi hizmetlerinden başlayarak, menopoz ve osteoporozdan, doğum kontrol yönetimlerine, riskli ve normal gebeliklerin takibine kadar pek çok alanda hizmet veriliyor. Özel Medlife Klinigi Bodrum
Ergenlikten başlayarak, menopoz dönemine kadar her yaştan kadının, tüm sağlık sorunlarının tanı ve tedavisinin yapılarak, rutin kontroller ile önleyici hekimlik uygulamalarının da başarıyla gerçekleştirildiği poliklinik hizmetleri veriliyor.
İlk Müdahale-Acil
MEDLIFE tıp merkezi olarak gelen hastamız değerlendirilerek ilk müdahale gerektirecek durumlarda serum takma, pansuman yapma, dikiş atma gibi müdahaleler bünyemizde verilmektedir.
Daha ileri düzeyde tedavi gereken hastalar ambulans ile daha ileri merkeze yönlendirilmektedir. Tıp merkezimizde Acil Servis bölümümüz de vardır.
Radyoloji
Radyoloji Nedir?
Radyoloji, hastalıkların tanı sürecinde ses, radyo dalgaları ve X işınları ile görüntüleme teknolojilerini kullanan, tedavi sürecinde görüntüleme teknikleri eşliğinde invaziv prosedürler içeren tıbbın son derece geniş kapsamlı dallarından biridir.
Yaptığı çalışmalar ile diğer tüm branşlara destek olan radyoloji, hastaları etkileyen pek çok tıbbî kararın hayatî bir bileşeni konumunda yer almaktadır. Radyoloji iki ana bölümden oluşmaktadır:
Tanısal Radyoloji (Diagnostik Radyoloji) Tanısal radyoloji, hastalık belirtilerini tespit etmek ya da alınan ilaçların tedaviye ne oranda yanıt verdiğini kontrol edebilmek için faydalanılan alt birimdir. En sık kullanılan ve kliniğimizde yer alan tanisal radyoloji testleri şunlardır:
- Ultrasonongrafi
- Doppler Ultrasonografi
- Röntgen
Tedavi ve Girişimsel Radyoloji
Tedavi ve girişimsel radyoloji, açık cerrahi operasyon uygulanmayan hastalıkların tedavisinde minimal invaziv prosedürler için görüntü rehberliği sağlayan sistem olarak tanımlanmaktadır. Ultrason gibi görüntüleme yöntemleri ile tıbbî prosedürleri yönlendirmeye yardımcı olmaktadır. Tedavi ve girişimsel radyoloji, genellikle damarlarda tıkanma,sırt ağrıları, böbrek ve karaciğer problemleri, kanser, tümör, rahim fibroidi gibi hastalıklarni tedavisinde etkin role sahiptir. Bu tür tedaviler, geleneksel operasyonlara göre daha az rıs’li, daha az ağrılı olmakta ve iyileşme süresini kısaltmaktadır. Tedavi ve Girişimsel Radyoloji prosedürlerine örnekler:
Meme biyopsisi, iğne biyopsileri, Köpükle varis tedavisi, RF ablasyon ile varis tedavisi Tanı ve tedavi planlaması konusunda radyolojide kullanılan birtakım yöntemler mevcuttur. Bu yöntemlerin temel amacı hastalığın doğru tanısının konması sürecinde yardımcı olacak sonuçlara ulaşmaktır. Özel Medlife Klinigi Bodrum
Kliniğimizde radyolojide kullanılan görüntüleme yöntemleri şunlardır: Ultrason: Radyoloji ile görüntüleme yöntemleri arasında ses dalgalarının kullanıldığı yöntemdir.
Üriner sisteme ait faaliyetleri, jinekolojik incelemeler, kain içi organlar gibi pek çok bölgede yapılan incelemede bu yöntem kullanılmaktadır. Bu inceleme yöntemi, hasta sağlığı açısından herhangi bir zarar oluşturmaz. – X Işını Kullanılan Görüntüleme Yöntemleri Röntgen: Vücut yapılarının ve özellikle kemiklerin, röntgen ışınları (X ışınları) kullanılarak görüntülenmesi yöntemidir. Panaromik röntgen: Diş ve ağız hastalıkları alanı için tercih edilen, ağız içinin tam anlamı ile görüntülendiği radyoloji yöntemidir.
Tedavi öncesinde plânlamarin mümkün hale getirilebilmesi için birçok doktor tarafından sıklıkla ihtiyaç duyulan bir görüntüleme yöntemidir.
Radyoloji Hangi Hastalıklara Bakar?
- Kemik ve akciğer hastalıklarının teşhisinde,
- Yaralanmalar ve acil tıpta,
- Meme hastalıklarında,
- Kalp ve damar hastalıklarının teşhis ve tedavisinde,
- Hamilelik takibinde,
- Yumuşak doku ve iskelet sistemi hastalıklarının teşhisinde,
- Omurga, omurilik, beyin, baş, boyun, bel, nöroradyoloji gibi sinir i temi kontrollerinde, Karin, batin, meme, yumuşak doku lezyonlarının görüntülenmesinde Jinekolojik ve pediatrik hastalıkların incelemesinde kullanılır.
Laboratuvar
MEDLIFE tıp merkezinde gelişmiş cihazlar ile tüm testler ve tahliller yapılmaktadır
Sağlık Raporu
MEDLIFE tıp merkezi bünyesinde
Ehliyet için sağlık raporu
Spor için sağlık raporu
İş için sağlık raporu
Amatör denizcilik belgesi için sağlık raporu
Havuz için sağlık raporu verilmektedir.
Çocuk Hastalıkları
Çocuk sağlığı ve hastalıkları kliniğimizde doğumdan sonra bebeklerin aylık olarak gelişimleri, ilk altı ay anne sütü ile beslenmenin desteklenmesi, altı ay sonrasında bebeğe ek gıda protokolünün başlatılması, baş, boyun, ağırlık ölçümleriyle çocuğun aylık gelişiminin takibi, aşılama takvimi takip edilmektedir. Özel Medlife Klinigi Bodrum
Ayrıca daha büyük çocuklarda da sağlıklı beslenme programı takip edilmektedir.
Çocuk Hastalıkları
Medlife Tıp Merkezimizde yeni doğan ve he yaştan çocuklarınız için , her türlü hastalık ve rutin
kontrollerde uzman doktorumuz ihtiyaç duyduğunuz her an yanınızda olacaktır.
- Yeni doğan Takibi
- Sağlam Çocuk Takibi
- Aşı Takibi ve Özel Aşıların Uygulanması
- Beslenme Takibi
- Emzirme Danışmanlığı
- İmmün Sistem Bozuklukları, Alerjik ve Astım Tanı ve Tedavisi
- İnfeksiyon Hastalıkları ( Bakteriyel, Viral, Paraziter Hastalıklar )Tanı ve Tedavisi
- Sindirim Sistemi Hastalıkları tanı ve Tedavisi
- Solunum Sistemi Hastalıkları Tanı ve Tedavisi
- İdrar yolu Hastalıkları Tanı ve Tedavisi
- Farwel Kulak Şekil Bozukluğu Düzeltme Sistemi Uygulaması
Ortopedi
Doğumsal ve edinsel ortopedik hastalıkların teknolojinin tüm imkanlarından faydalanarak bilimsel çerçevede çözüme kavuşturulması oldukça önemlidir. Hareket sistemimiz bu anlamda ağrısız bir şekilde hareket etme yeteneğine sahiptir. Özel Medlife Kliniği Bodrum
Dinlenme veya efor esnasında sürekli ağrıların meydana gelmesi bir rahatsızlık belirtisidir. Ağrıya bağlı olarak yapılamayan veya işlevselliğini yitiren hareketler patolojik bulgular kapsamına alınmalı ve buna göre ortopedi alanının kapsamında tedavilere tabi tutulmalıdır.
Bunun yanı sıra kas gücünde azalma, his kaybı, sinirsel fonksiyon bozuklukları, iskelet sisteminde yaralanmaya veya doğuma bağlı olarak gelişen bozuklukların hepsi ortopedinin inceleme alanındadır.
Buradan hareketle ortopedi başlığı altında ilgi alanlarını aşağıdaki gibi sıralayabiliriz.
- Travma olguları
- Artroskopik diz
- Omuz ve ayak bileği cerrahisi
- Spor yaralanmaları
- Kalça ve diz eklem protezleri
Kulak Burun Boğaz
MEDLIFE Tıp Merkezi bünyesinde Kulak Burun Boğaz hastalıkları servisi bulundurmaktadır.
Dermatoloji
Dermatoloji, deri ve mukoza hastalıklarının tanı ve tedavisi ile ilgilenen bilim dalıdır. Deri ekleri olarak tanımlanan saç ve tırnak hastalıkları da dermatolojinin ilgi alanına girer. Dermatolojinin ilgilendiği bir başka konu ise ‘Zührevi’ yani ‘Cinsel Yolla Bulaşan’ hastalıklardır.
Sık görülen dermatolojik hastalıklar arasında; Deri Enfeksiyonları (derinin mantar hastalıkları, siğiller, dolama…), Yağ Bezi Hastalıkları (sivilce, saçlı deride kepeklenme…), Allerjik Deri Hastalıkları (atopik egzema, temas allerjileri, böcek ısırıkları…), İlaç Reaksiyonları, Ürtiker (Kurdeşen), Psoriasis (Sedef Hastalığı), Vitiligo (Ala hastalığı), Deri Tümörleri, İleri derece olmayan yanıklar, Saç Hastalıkları, Tırnak Hastalıkları, Aşırı Terleme, Cinsel Yolla Bulaşan Hastalıklar (Frengi, genital siğil…) sayılabilir.
Göğüs Hastalıkları
Göğüs Hastalıkları Nelerdir?
Göğüs Hastalıkları Bölümü; solunum sistemi ve akciğerleri ilgilendiren tüm hastalıkların tetkik, tanı, tedavi ve takibini yapan tıbbi branştır. Günlük yaşamı kısıtlayan, yaşam kalitesini düşüren ve solunum fonksiyonlarını etkileyen pek çok hastalık bu bölüm kapsamında değerlendirilir.
Öksürük, göğüs–sırt–omuz ağrıları, hırıltılı solunum, balgam, horlama, öksürükle birlikte kan gelmesi, halsizlik, gece terlemeleri, ateş, iştahsızlık ve kilo kaybı gibi şikâyetlere yol açan hastalıklar göğüs hastalıkları uzmanları tarafından takip ve tedavi edilir.
Göğüs Hastalıkları kapsamında değerlendirilen başlıca hastalıklar şunlardır:
- Akciğer embolisi
- Akciğer kanseri
- Alerjik akciğer hastalıkları
- Kronik öksürük
- Obstrüktif akciğer hastalıkları (astım, bronşektazi, KOAH)
- Akciğer zarında sıvı birikmesi (plörezi)
- Pnömotoraks (akciğer sönmesi)
- Pnömoni (zatürre)
- Sarkoidoz
- Sigara bağımlılığı, sigarayı bırakma süreçleri ve sigaraya bağlı gelişen hastalıklar
Tanı sürecinde hekim, öncelikle hastanın ayrıntılı öyküsünü dinler ve fizik muayenesini gerçekleştirir. Gerekli görüldüğünde radyolojik görüntüleme yöntemleri (akciğer grafisi, tomografi vb.) ve laboratuvar testleri istenir. Hastanın durumuna göre solunum fonksiyon testleri gibi ek incelemeler de yapılabilir.
Tanı konulduktan sonra, hastalığın türü ve şiddetine bağlı olarak kişiye özel tedavi planı oluşturulur. Tedavi süreci; ayaktan takip veya gerekli durumlarda yatarak tedavi şeklinde planlanır. Amaç, solunum fonksiyonlarını iyileştirmek, şikâyetleri azaltmak ve hastanın yaşam kalitesini artırmaktır.
Evde Bakım Hizmetleri
Değerli büyüklerinizin bakımı için en iyi yaşlı bakıcı ve bakımıyla sizlerleyiz! Zaman Sağlık danışmanlık olarak en iyi yaşlı bakıcı hizmetini sunuyoruz
Evde Bakım Hizmetleri ile ilgili detaylı bilgi almak için aşağıdaki numaralardan herhangi birini arayarak bizimle iletişime geçebilirsiniz. Özel Medlife Klinigi Bodrum
SSS (Sık Sorulan Sorular)
S: Medlife Tıp Merkezi SGK ile anlaşmalı mı?
C: Evet. Medlife Tıp Merkezi’nde SGK kapsamında hizmet verilmektedir. Ayrıca SSK, Bağ-Kur ve Emekli Sandığı kapsamındaki hastalar ile kurum anlaşmaları bulunmaktadır. Özel Medlife Klinigi Bodrum
S: Randevu nasıl alabilirim?
C: Telefonla arayarak randevu oluşturabilirsiniz. Ayrıca Medlife’ın online randevu sistemi üzerinden de randevu alınabildiği duyurulmaktadır. (Instagram)
S: Acil servis var mı?
C: Evet. Acil servise başvuran hastalar, sağlık güvencesi veya ödeme durumuna bakılmaksızın değerlendirilir. Kliniğin “sadece acil” günleri de bulunmaktadır. (medlifetipmerkezi.com)
S: Laboratuvar hizmetiniz var mı? Kan tahlili yapılıyor mu?
C: Evet. Merkez bünyesinde laboratuvar hizmeti vardır; kan testleri ve birçok tetkik yapılmaktadır. “7/24 laboratuvar” hizmeti bilgisi de paylaşılmaktadır. (medlifetipmerkezi.com)
S: Sonuçlar aynı gün çıkar mı?
C: Yapılan tetkike göre değişmekle birlikte, birçok test sonucunun aynı gün çıkabildiği belirtilmektedir. Özel Medlife Klinigi Bodrum
S: Çalışma saatleriniz nedir?
C: Hafta içi farklı günlerde saat aralıkları değişmektedir; Cumartesi ve Pazar “sadece acil” olacak şekilde çalışma saatleri bilgisi yayınlanmıştır. (medlifetipmerkezi.com)
S: Medikal estetik bölümünüz var mı?
C: Evet. Medlife Tıp Merkezi’nde medikal estetik uygulamaları bulunmaktadır.
S: Hangi poliklinik/branşlarda hizmet veriyorsunuz?
C: Merkezde; Kardiyoloji, Dahiliye (İç Hastalıkları), Genel Cerrahi, Kadın Hastalıkları ve Doğum, Göz, Kulak Burun Boğaz, Ortopedi ve Travmatoloji, Fizik Tedavi ve Rehabilitasyon, Radyoloji ve Laboratuvar gibi birçok branşta hizmet verilmektedir. (Bodrum Ticaret Odası)
S: Radyoloji bölümünde hangi görüntüleme hizmetleri var?
C: Merkezde radyoloji kapsamında ultrason ve röntgen gibi görüntüleme hizmetleri sunulduğu belirtilmektedir.
S: Sağlık raporu veriyor musunuz?
C: Evet. Ehliyet, spor, iş, amatör denizcilik belgesi ve havuz gibi amaçlarla sağlık raporu düzenlenebilmektedir.
S: Adresiniz nerede?
C: Konacık Mahallesi, Atatürk Bulvarı No:203/B, Bodrum / Muğla (Bitez Kavşağı).
S: İletişim bilgileri nedir?
C: Telefon: 0 252 363 77 76 / 0 252 363 00 79 / 0 543 627 74 01 — E-posta: info@medlifetipmerkezi.com — Web: medlifetipmerkezi.com
Medlife Tıp Çalışma Saatleri 7/ 24
📞 İletişim Bilgileri
☎ Telefon
0 252 363 77 76
0 252 363 00 79
0 543 627 74 01
✉ E-posta
info@medlifetipmerkezi.com
🌐 Web Sitesi
medlifetipmerkezi.com
📍 Adres
Konacık Mahallesi, Atatürk Bulvarı No:203/B Bodrum / Muğla – Bitez Kavşağı
